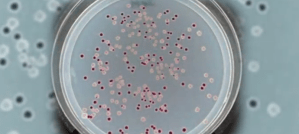

One thing I’ve come to recognize in my years studying the Creation vs. Evolution debate is that there seems to be a noticeable disconnect, and this article from Discover provides a case study.
A little over thirty years ago (1988), Richard Lenski began growing bacteria in his lab, and his experiment became famous… one of “epic proportions”! It is said to offer “unprecedented insights into the mechanics of evolution”. But does it really?
The famous Lenski E. coli experiment has been promoted by evolutionists as evidence for evolution. Why? Because Lenski was able to track mutations and identify their associated physical traits, all in an attempt to understand how evolution works.
But wait, here comes the disconnect: creationists love the implications of this experiment too. And why is that? Well, it’s because it actually provides compelling evidence against evolution! Really? How so? Well, to make a long story short, after 70,000 generations of bacteria, the bacteria are still… bacteria…yeah.
You’d think after 70,000 generations, the bacteria would have evolved into a different kind of organism. Consider, humans and apes supposedly branched off from our closest living relative anywhere from 3 to 13 million years ago (depending on the source). If we can figure out how many generations have passed since that split, then we can begin to see that something isn’t adding up. After 70,000 generations from our last common ancestor, evolutionists would claim there had to have been a considerable amount of evolution- from cranial capacity to bipedalism to body type. In that amount of time, many different kinds of hominids (i.e. australopithecines) have come and gone. If we use the figure of 20 years per generation, then about 150,000 to 650,000 generations have passed since our last common ancestor, or an equivalent of 1,400,000 years of human evolution.
So then, where is the evolution in Lenski’s experiment? We should see the bacteria evolving into something else by now, right? But they haven’t. Why is that? Answer: because they can’t. But why not? Because evolution is fictional and not scientific.
Evolutionists, however, don’t see it like that. From their perspective, the bacteria have been evolving before our very eyes. What they see are beneficial mutations being incorporated into the bacteria’s genetic makeup and passed on to future generations. The bacteria are considered more fit based on how quickly they reproduce. But what they don’t see is that the E. coli are still E. coli and haven’t evolved into anything else.
Let me offer a few things to consider: first, E. coli has always had the ability to eat citrate (under anaerobic conditions); it’s just that they couldn’t do so aerobically. And as Lenski discovered, it took “a specific series of mutations” for this to happen. So, if the ability to digest citrate was present from the beginning, is this really an example of evolution? I would say not.
Second, when they claim the bacteria are more fit, that’s only true in the lab. The bacteria would have a tough time competing in their natural habitat because they’re actually less fit than the E. coli found in the wild. And why is that? Because mutations have caused them to lose the ability to survive in the wild; in essence, the bacteria adapted to the lab by getting rid of genes that were dead weight, so this can’t be an example of evolution. The loss of ability doesn’t require the evolution of new genetic information. So then, is this really evolution, and does it explain how a single celled organism evolved into humans over several billion years? No, it certainly doesn’t. The bacteria only survive because, in their current environment, they have no competition and are cared for.
Third, it helps to understand how evolution is being defined. The term ‘evolution’ is so elastic that it can mean just abut anything, and I think that’s why some people accept it without skepticism. In this article, evolution simply means any kind of change from one generation to the next. If we accept that definition, then evolution is scientific because these changes can be observed and experimented upon. But the kind of evolution we should be skeptical of is when it is assumed, or believed by faith, that one organism (a deer-like mammal) can change into another (whale) without any observable evidence to back it up. The general theory of evolution claims that all life today is related to a single common ancestor, and that is what we should be skeptical of (if not soundly rejected).
Again, evolutionists want to convince us that we evolved from hominids (like Sahelanthropus, Orrorin, Ardipithecus and Australopithecines) between 4-7 million years ago, yet, after more than 70,000 generations, a simple line of bacteria remains bacteria with no sign of becoming anything else. If bacteria can’t evolve into something else after 70,000 generations, why should we believe humans evolved from something else?
Needless to say, we can’t observe the kind of evolution evolutionists claim happened millions of years ago, nor can we conduct any experiments on the past to confirm their claims. Yet they expect us to accept evolution by faith. But the nice thing about the Lenski experiment is that we can confirm the bacteria did not evolve into any other kind of organism.
So then, what did Lenski observe? “Billions of changes”. The current line of bacteria reproduces about 70 percent faster than previous generations. What made Lenski’s experiment so popular is the discovery that the E. coli “evolved” the ability to eat citrate. But isn’t that evolution? No, not really; not unless you define evolution as any kind of change without regard for how one kind of organism evolves into another, (i.e. dinosaur to bird evolution).
Let me offer an explanation: what Lenski has observed over the years is mostly a loss of information, and the author admits this, explaining that other populations of bacteria could have “evolved” the ability to eat citrate, but the wrong mutation throws it off course, into “an alternate universe whose doors have shut forever.” In other words, once a mutation happens, it can’t be undone, and the function is lost. Only if all the right mutations occur in the right order can other populations eat citrate. And that’s what happened with the famous strand.
More specifically, Lenski has observed mutations leading to defects in DNA repair, mutations that knock out genes, mutations causing a loss of function, mutations causing a decrease in protein function, mutations disrupting function, gene mutations rendering protein products nonfunctional, and, in the classic case of E. coli “evolving” the ability to eat citrate, we have a genomic region replicated. That’s it. A previously existing promoter was captured, and evolutionists want us to believe that that proves an ape-like creature could evolve into a human. But what they fail to mention is that such a replication doesn’t explain how a functional promoter originated in the first place. The event occurred with existing material. But the classic theory of evolution requires new, novel information at the genetic level, and Lenski’s experiment doesn’t do that.
So how, exactly, does this experiment offer any insight into the mechanics of evolution? It doesn’t. I’d suggest all it really does is help explain how biology works, which is actually quite helpful. It explains why this bacterium is able to reproduce as quickly as it does. But it doesn’t explain what they think it does.
Now that we know what they did observe, we can ask, “What didn’t they observe”? Answer: evolution. They observed changes within the bacterium, and mutations, but let’s not confuse those changes with evolution. If we do, it becomes a type of ‘bait-and-switch’ tactic.
Another point to consider; I’ve had evolutionists tell me that evolution doesn’t have to occur at all. They make this claim because, supposedly, we can see no change in many organisms over millions and billions of years. But, if we’re to believe the evolutionary experimentation in this article, then those evolutionists are wrong because Lenski has proven that evolution never stops, right? No, of course not. He’s actually contradicting evolutionary conventional wisdom.
The article also points out that there have been many long-term evolution experiments over the last 200 years. Scientists have watched microbes, corn and fruit flies “evolve”, yet they don’t seem to realize that they didn’t really evolve if they’re still microbes, corn or fruit flies.
Another great quote to ponder: “Over thirty years in, Lenski’s data indicates that in another 30 years, or 300, the bacteria will still be replicating faster than they were the day before. The supply of beneficial mutations looks inexhaustible.”
Can you identify the mistake? Assuming the author believes in evolution, he fails to predict that the bacteria will evolve into some other kind of organism over time. No, he predicts the bacteria will still be bacteria, and the mutations will continue allowing them to reproduce faster. So, what does this mean for evolution? It’s dead. When confronted with reality and observable evidence, evolutionists reject evolution.
Therefore, for anyone to consider this experiment as something that provides “unprecedented insights into the mechanics of evolution,” that notion seems false.
On the other hand, I think this experiment does a wonderful job describing how well bacteria- and all life- have been created and designed to function. God created organisms to reproduce after their kind, and this is exactly what we observe.
I welcome any Evolutionist to sterilize his lab. introduce all the chemicals etc. he wants all the hydro and all the machinery. Just one thing. He cant start with Gods work. He has to make his own. So no taking any living thing into the room.
—
Nothing fails like Evolution.
Exactly! 🙂
Reblogged this on Jesus Christ is Salvation and commented:
Evolution is a Hoax and this is just another nail in the coffin. Evolving Bacteria that doesn’t really evolve.
Thanks Jonathan for your great Op.
You’re very welcome. And thanks for reblogging! Hope you had a Merry Christmas 🙂
Pingback: Lenski’s 30 Year Experiment – Jesus Christ is Salvation
Following you now. Chris. Very fun to read.
Thanks, much appreciated!